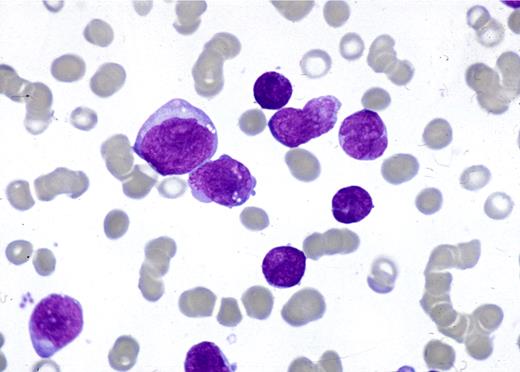
Figure 1. May-Grunwald-Giemsa–stained BM smear showing a mixed-cell population of large and small blasts.

Abstract
The features of 100 mixed-phenotype acute leukemias (MPALs), fulfilling WHO 2008 criteria, are documented. Myeloid and T-lineage features were demonstrated by cytoplasmic myeloperoxidase and CD3; B-lineage features were demonstrated by at least 2 B-lymphoid markers. There were 62 men and 38 women; 68% were adults. Morphology was consistent with acute lymphoblastic leukemia (ALL; 43%), acute myeloid leukemia (AML; 42%), or inconclusive (15%). Immunophenotyping disclosed B + myeloid (59%), T + myeloid (35%), B + T (4%), or trilineage (2%) combinations. Cytogenetics evidenced t(9;22)/(Ph+) (20%), 11q23/MLL rearrangements (8%), complex (32%), aberrant (27%), or normal (13%) karyotypes. There was no correlation between age, morphology, immunophenotype, or cytogenetics. Response to treatment and outcome were available for 67 and 70 patients, respectively; 27 received ALL, 34 AML, 5 a combination of ALL + AML therapy, and 1 imatinib. ALL treatment induced a response in 85%, AML therapy in 41%; 3 of 5 patients responded to the combination therapy. Forty (58%) patients died, 33 of resistant disease. Overall median survival was 18 months and 37% of patients are alive at 5 years. Age, Ph+, and AML therapy were predictors for poor outcome (P < .001; P = .002; P = .003). MPAL is confirmed to be a poor-risk disease. Adults and Ph+ patients should be considered for transplantation in first remission.
Introduction
Biphenotypic acute leukemia (BAL) is a very rare disease possibly arising from a hemopoietic pluripotent stem cell.1 The diagnostic criteria until now were based on the scoring system proposed by the European Group for the Immunological classification of Leukemias (EGIL)2 that was adopted by the WHO 2001 classification.3 Single case reports and limited data in small series of patients classified according to the EGIL criteria have been documented.4-12 A significant number of other cases reported as BAL, did not fulfill the EGIL criteria and instead represented acute lymphoblastic (ALL) or myeloid leukemias (AML) with aberrant antigen expression of differentiation antigens from another lineage.13-16
The most recent edition of the WHO classification has established and published new criteria for the diagnosis of BAL. It has also adopted a new designation for this disease, now termed mixed-phenotype acute leukemia (MPAL).1 The previous criteria have been refined to ensure that cases of “bona fide” ALL or AML with aberrant antigen expression, AMLs with recurrent chromosomal abnormalities, or chronic myeloid leukemia (CML) in blast crisis are excluded. Moreover, therapy-related myeloid neoplasms and AML with myelodysplasia-related features should be classified as such, even when they have an MPAL immunophenotype. Briefly, the WHO definition of MPAL is based on the expression of strictly specific T-lymphoid (cytoplasmic CD3) and myeloid (myeloperoxidase [MPO]) antigens, the latter shown by either flow cytometry (FCM) or cytochemistry and/or clear evidence of monocytic differentiation. Because there is no single antigen strictly specific for B cells, B-cell lineage assignment in MPAL relies on the strong expression of CD19 together with another B cell–associated marker or, in cases with weak CD19, on the expression of at least 3 B-lineage markers.1 In addition, the WHO recognizes 2 distinct categories: MPAL with the t(9;22)(q34;q11)/BCR-ABL1 and MPAL with t(v;11q23)/MLL rearrangement. The remaining cases are designated as MPAL NOS (not otherwise specified).
The rarity of MPAL and the lack of uniform diagnostic criteria applied in the cases reported thus far have made it difficult to establish whether these leukemias have distinct characteristics and which is the best therapeutic approach for these patients. Thus, there is no robust information on the clinical and biologic features of cases with MPAL as defined by the recently updated WHO criteria.1 This is the first report documenting the demographics and the clinical and laboratory features, including cytogenetics and outcome of a large series of 100 patients, retrospectively collected by the EGIL group and classified according to the WHO 2008 criteria.
Methods
Case selection
This study included 100 patients diagnosed with MPAL according to the recent WHO criteria.1 They were selected from the archives of acute leukemias over a 15-year period and the majority of patients presented over the last 5 years. Most cases were from United Kingdom (64), Austria (21), and Holland (8), and a minority were from France (3), Sweden (2), Spain (1), and Czech Republic (1). Among the acute leukemias, the frequency of MPAL in the participating centers was 0.5%-1%. Cases were classified as ALL or AML by morphology and cytochemistry for MPO, Sudan black B (SBB), and nonspecific esterases according to the French-American-British (FAB) criteria.17 Cytogenetic analysis was carried out in 76 cases and fluorescence in situ hybridization (FISH) and/or molecular analysis to detect BCR-ABL1, ETV6-RUNX1, and MLL rearrangements in 14, 8, and 7 cases, respectively. Cases with acute promyelocytic leukemia, those with AML with recurrent chromosome translocations, that is, t(8;21) or inv(16), CML in blast crisis, AML after myelodysplasia, and cases fulfilling the EGIL criteria but being MPO-negative were excluded.
Flow cytometric immunophenotyping
FCM immunophenotyping was performed on either isolated bone marrow (BM) mononuclear cells or in whole BM specimens after lysis according to standard techniques. Before 2000, the blast population was identified by a forward scatter (FSC) and side scatter (SSC) gate and thereafter on CD45int/low blast cells versus SSC. According to each center's protocols, multiparameter immunostaining with fluorochrome directly labeled monoclonal antibodies (MoAbs) was performed. Surface antigen expression was considered positive if at least 20% of blasts showed a positive labeling.2 For cytoplasmic antigen expression, the threshold was 10%. If findings by FCM were equivocal, confirmation of the staining by immunocytochemistry was carried out. The specificity of MPO staining was validated by cytochemistry and false-positives because of autofluorescence were ruled out. The core of MoAbs investigated comprised: cytCD3, CD2 and CD7 for the T-cell lineage, anti-MPO, CD13 and CD33 and CD117 for the myeloid lineage and CD19, CD10, cytCD22 and/or cytCD79a for the B-lymphoid lineage. The majority of cases were also investigated for the expression of nuclear TdT, CD34, and HLA-DR and a substantial proportion for CD14, anti-lysozyme, CD15, CD65, and cytoplasmic μ chain.
Cytogenetics
Conventional karyotypic studies were carried out on BM cells after 24- to 48-hour culture in tissue-culture medium according to standard techniques. A complex karyotype was defined when 3 or more clonal structural chromosomal abnormalities were present. FISH analysis for the BCR-ABL1, ETV6-RUNX1, and MLL rearrangements was carried out using commercial probes according to manufacturer's instructions and following standard techniques.
Statistics
The χ2 and Fisher exact tests were used for the analysis of clinical and laboratory variables. Survival curves were calculated by the Kaplan-Meier method and differences between groups were assessed by the log-rank test.
Results
Patients
There were 62 men and 38 women (men/women: 1.6). Twenty-eight (28%) patients were children, 2 of whom were infants (< 1-year old) and 68 (68%) were adults (> 15-years old); the age of 4 patients was not available. There was no selection for treatment. In each country, patients were treated according to national protocols for ALL or AML and these included the same drugs and similar regimens. Complete remission (CR) was considered by standard morphology and recovery of the blood counts.
Morphology
Review of peripheral blood and BM smears for morphology and cytochemistry was performed in 90 cases. According to the FAB criteria, 39 cases displayed an ALL morphology and cells from 2 of these cases (1 with T-lineage + myeloid commitment and another with T and B-lymphoid involvement) had a cytochemical reaction for acid phosphatase with a dot pattern characteristic of T-ALL. Thirty-eight cases were classified as AML, namely M1 and M5 and rarely M2 or M4 according to FAB; no single case was M3, M6, or M7 or had a dysplastic background. The remaining 13 cases had a dual population of small and large blasts difficult to classify by morphology and were categorized as undifferentiated acute leukemia (AUL; Figure 1).
May-Grunwald-Giemsa–stained BM smear showing a mixed-cell population of large and small blasts.
May-Grunwald-Giemsa–stained BM smear showing a mixed-cell population of large and small blasts.
Flow cytometric immunophenotyping
Immunophenotyping showed that 59 (59%) cases had a B-lymphoid + myeloid immunophenotype (B + My), 35 (35%) a T-lymphoid + myeloid immunophenotype (T + My), 4 (4%) a B + T-lymphoid immunophenotype (B + T), and in the remaining 2 cases (2%) there was evidence of trilineage concomitant expression (myeloid, B, and T lymphoid [My + B + T]; Table 1). There were no significant differences between B + My and T + My immunophenotypes for age (P = .2), sex (P = .7), and morphology (P = .2). However, 3 of the 4 patients with the B + T immunophenotype were children and the 2 cases with trilineage differentiation were adults. All 4 patients with a B + T immunophenotype and the 2 with a My + B + T immunophenotype had an ALL morphology.
TdT was positive (> 10% blasts) in 81 of 91 (89%) cases. The 10 TdT-negative cases corresponded to 7 patients with a T + My immunophenotype, 2 with a B + My immunophenotype, and 1 with a B + T immunophenotype. The intensity of TdT staining in the MPAL was not different from that seen in ALL cases (data not shown). HLA-DR was strongly positive in 62 of 67 (92%) and CD34 in 62 of 83 (74%) cases. Results of other antigen expression are described in the next section according to the myeloid and T- and B-lymphoid commitment.
Myeloid commitment in cases with B + My and T + My immunophenotype
The MoAb anti-MPO was expressed in at least 5% of blasts in 90 (98%) of 94 cases and in more than 20% of blasts in 69 (76%) cases. Four cases were not tested by FCM but 5%-9% of blasts were positive for MPO and SBB by standard cytochemistry. Therefore, there was evidence of myeloid commitment in all cases. There was a variable proportion of blasts (5%-95%) coexpressing anti-MPO and lymphoid markers in all but the 4 patients in whom only MPO cytochemistry was available and double staining could not be performed.
In our cohort of patients, CD13 was positive in 70 (74%) of 94 and CD33 in 62 (66%) of 94. All except 9 cases expressed MPO together with CD33 and/or CD13 (see EGIL scores). Expression of other myelo-/monocyte-associated markers was as follows: CD14 in 4 (8%) of 48, CD15 in 6 (12%) of 52, lysozyme in 13 (31%) of 42, and CD117 in 34 (52%) of 65 cases.
T-lymphoid commitment in cases with a T + My immunophenotype (Figure 2)
Dot plots with the blast population highlighted in blue (R1) and lymphocyte population in green (R2). These dot plots demonstrate the expression of CD13 and CD33 and coexpression of MPO with cytCD3. Residual T lymphocytes are positive for cyt.CD3 but MPO-negative. CD19 and CD7 are negative.
Dot plots with the blast population highlighted in blue (R1) and lymphocyte population in green (R2). These dot plots demonstrate the expression of CD13 and CD33 and coexpression of MPO with cytCD3. Residual T lymphocytes are positive for cyt.CD3 but MPO-negative. CD19 and CD7 are negative.
Cytoplasmic CD3 (cytCD3) was expressed in all 35 cases. The proportion of positive blasts ranged from 13% to 99%, and 31 (88%) of 35 cases had more than 20% of cytCD3+ blasts. In 4 cases, only a small minority of blasts coexpressed cytCD3 and anti-MPO. CD2 was positive in 27%-98% of blasts from 20 (67%) of 31 and CD7 in 24%-99% of blasts from 30 (91%) of 33 cases tested. The expression of other lymphoid-lineage–associated markers was as follows: CD10 in 4 (16%) of 25 and weak expression of CD79a in 4 (27%) of 15. In the 4 cases with less than 20% cytCD3+ blasts, other lymphoid markers were expressed in higher proportions (> 50%) as follows: CD2 (3 of 3), CD7 (2 of 3), CD10 (1 of 2), and weak CD79a in the single case tested.
B-lymphoid commitment in cases with B + My immunophenotype
CD19 54 (93%) of 59 cases and the proportion of positive blasts was greater than 50% in 45 cases. In all of them, the blasts were positive for CD10, cytCD22, and/or cytCD79a. In 5 cases, CD19 was weak or expressed in less than 20% of blasts, but the cells in 2 of them strongly expressed CD10 and cytCD22. In another 2 cases cytCD22 and cytCD79a were positive and the immunophenotype in the remaining case was cytCD22, cytCD79a, and cytoplasmic μ chain positive. Expression of other lymphoid markers in this whole group was as follows: CD10 in 33 (64%) of 53, cytCD22 in 45 (85%) of 54, cytCD79a in 34 (86%) of 38, and cytoplasmic μ chain in 17 (40%) of 42 cases (Figure 3).
Dot plots with the blast population highlighted in red (R1) and lymphocyte population in green (R2). These dot plots demonstrate the expression of CD13 and coexpression of MPO with CD19. Other positive markers are CD34, CD79a, and TdT. CD7, CD15, and lysozyme are negative
Dot plots with the blast population highlighted in red (R1) and lymphocyte population in green (R2). These dot plots demonstrate the expression of CD13 and coexpression of MPO with CD19. Other positive markers are CD34, CD79a, and TdT. CD7, CD15, and lysozyme are negative
Cases with a B + T-lymphoid immunophenotype and trilineage differentiation (Figure 4)
Infinicyte band representation. (A) Of merged files showing intracytoplasmic expression of CD3 and CD79a but negative MPO and (B) of merged files showing membrane expression of CD10, CD19, and CD7 with weak expression of CD34 and HLA-DR in the same case (B + T-lymphoid phenotype). There is lack of expression of CD117.
Infinicyte band representation. (A) Of merged files showing intracytoplasmic expression of CD3 and CD79a but negative MPO and (B) of merged files showing membrane expression of CD10, CD19, and CD7 with weak expression of CD34 and HLA-DR in the same case (B + T-lymphoid phenotype). There is lack of expression of CD117.
Blasts in all 4 B + T-lymphoid cases expressed CD19 strongly together with 1 or more B-lymphoid markers. A high proportion of blasts from 3 cases expressed cytCD3, all were CD2+ and 3 of 4 CD7+; in the remaining case, the proportion of cytCD3+ blasts was low but confirmed by immunocytochemistry and double immunostaining with TdT and cytCD3. TdT was positive in 3 cases and CD34 in 1. All but 1 were adults and 3 had an abnormal karyotype (see “Cytogenetics”). The majority of blasts in the 2 cases with trilineage differentiation were positive with 4 B-lymphoid markers, the 3 T-lymphoid markers, and anti-MPO + 1 or 2 myeloid markers. These 2 patients were adults with ALL morphology and 1 had a Ph+ chromosome with an additional iso(9)(q10).
EGIL scores
We analyzed whether the MPAL cases included here according to the WHO could have been classified as BAL on the basis of the EGIL scoring system. All cases with B-lymphoid commitment scored for this lineage 2.5 (8 cases) or greater and cases with T-lymphoid commitment had scores of 2.5 (6 cases) or greater. Regarding the myeloid commitment, all but 9 cases scored more than 2. Cells from the 9 cases that scored only 2 had evidence of myeloid commitment by both immunostaining with anti-MPO and cytochemistry but were negative for other myeloid markers and/or not all the myeloid-associated markers were tested and therefore they would have not been classified as BAL according to the EGIL criteria.
Cytogenetics
Of the 76 patients in whom cytogenetic information was available, 15 (20%) had the t(9;22)(q34;q11) (Ph+) confirmed by FISH in 5 cases and with 4 of them having additional chromosomal abnormalities. Six (8%) cases had translocations involving the 11q23 breakpoint (MLL gene) of which 3 had t(4;11)(q21;q23), 2 t(11;19)(q23;p13), and 1 t(9;11)(p22;q23). In 2 of the latter cases, the karyotype was complex with additional abnormalities. FISH analysis confirmed the presence of the fusion genes MLL-AF4 (2 cases) or MLL-AF9 (1 case) in all 3 of these cases investigated. Twenty-four cases (32%) had a complex karyotype with 3 or more structural chromosome abnormalities, 21 (27%) had other abnormalities including 2 patients with a hyperdiploid karyotype, and 10 (13%) a normal karyotype (Table 2). The most commonly involved chromosomes in cases with a complex karyotype were: del(6)(q11-21) in 4 cases, structural or numerical abnormalities of chromosome 7 [7q−, −7, or t(2;7)] in 5 cases and del(5q) or −5 in 3 cases. Among the cases with other abnormalities, there were 2 patients with trisomy 4, 2 with a hyperdiploid karyotype, and in 2 others FISH detected an ETV6-RUNX1 rearrangement that had been suspected by cytogenetics in 1 of them that had t(11;12;21)(p11;p13;q22). There was no evidence of BCL-ABL1 or MLL rearrangements in 3 cases investigated by FISH.
The relationships between karyotype and age, morphology, and immunophenotype subtypes are shown in Table 2. Although the presence of Ph+ was more frequent in adults with a B + myeloid immunophenotype and MLL rearrangements were more often seen in children and patients with a B + myeloid immunophenotype, the differences were not statistically significant (Ph+ vs other abnormalities P = .2 and Ph+ vs phenotypes, P = .4). There was no significant correlation between age (P = .3), sex (P = .2), cell morphology (P = .8), FAB subtype, or immunophenotype (P = .2) and the presence of a complex karyotype, other clonal abnormalities, or a normal karyotype.
Response to therapy and outcome
Information on response to first-line treatment was available for 67 patients; 1 infant (3-weeks old) did not receive treatment and died within a month. Of the 67 patients, 27 received therapy for ALL, 34 were treated with AML schedules with the addition of imatinib in 2, 5 had a combination of ALL and AML drugs, and 1 patient received only imatinib. Twenty patients underwent autologous or allogeneic stem cell transplantation. CRs to ALL treatment were achieved in 23 (85%) of 27 but in 3 of these patients the responses were of short duration and an early relapse occurred; 4 patients did not respond. Fourteen (41%) of the 34 patients treated with AML therapy achieved a CR, 15 did not respond and 3 were nonevaluable because of early death; the response was not recorded in 2 patients. Three of the 5 patients treated with a combination of ALL/AML drugs achieved a CR and the remaining 2 were nonevaluable as they died in the aplastic phase because of fungal infection and bleeding, respectively. The single patient treated with imatinib did not respond.
At the time of the last follow-up, 40 (58%) of 70 patients have died, most (33; 81%) from progressive/resistant or relapsed disease, 6 from complications, and 1 from a brain tumor unrelated to the leukemia (Table 3). The overall median survival for this series was 18 months and survival at 5 years was 37% (Figure 5A). Age, Ph+, and type of induction therapy were significant strong predictors for survival (Figure 5B-D). Median survival for children was 139 months versus 11 months for adults (P < .001), 8 months for Ph+ versus 139 months for patients with normal karyotype, 28 months for other abnormalities and not reached for those with complex karyotype and MLL rearrangements (P = .002), and 11 months for those treated with AML schedules versus 139 months for those treated with ALL-type drugs (P = .003; Figure 5B-D).
Overall survival of MPAL patients. (A) Overall survival for the whole MPAL series. (B-D) The median survival of patient groups established according to age (B), cytogenetics (C), and the type of induction therapy (D).
Overall survival of MPAL patients. (A) Overall survival for the whole MPAL series. (B-D) The median survival of patient groups established according to age (B), cytogenetics (C), and the type of induction therapy (D).
Discussion
The majority of acute leukemias can be classified as myeloid, B, or T lymphoid in origin according to the antigenic profile of the blasts. However, lineage assignment in a minority of cases is not possible because of the evidence of expression of both lymphoid and myeloid lineage-specific antigens in the blast cells. These cases have been described in the literature as BAL or mixed-lineage acute leukemias and, recently, the designation of MPAL has been proposed by the WHO.1
Information on characteristic features of MPAL is very limited because of the rarity of these leukemias and to the new criteria established for its definition. Thus, a substantial number of publications refer to data on patients with miscellaneous diagnoses12-16,18,19 and/or including true MPAL together with some cases that would not fulfill the present WHO criteria.4,10,11,19,20
We document for the first time the disease features on a large series of acute leukemia cases classified as MPAL according to the strict criteria established by the WHO 2008.1 Our data show that MPAL includes rather heterogeneous acute leukemia cases. It affects both adults and children, including infants, although it seems more frequent in adults. There is a slight male predominance. There was no correlation between immunophenotypic subtypes and sex or age. Morphologically, MPAL is heterogeneous and most patients present either as ALL or as AML with or without myeloid or monocytic differentiation features. Thus, a diagnosis of MPAL is unlikely to be suspected by morphology except for the small subset in which there is evidence of a distinct dual-blast population with either lymphoid or myeloid features. Therefore, the diagnosis of MPAL always relies on immunophenotyping and exclusion by cytogenetics of AML cases with recurrent abnormalities and by morphology that rules out the presence of a dysplastic background.
From a practical perspective and to establish a diagnosis of MPAL, we would recommend the use of a minimal battery of MoAbs that should include: anti-CD3, anti-CD19 plus 3 other B cell–associated markers (CD22, CD79a, CD10), anti-MPO (cytochemistry and FCM), and 2 or 3 monocytic-associated markers such as CD14, CD11c, CD64, CD36, or anti-lysozyme.1 Lysozyme cannot be considered fully specific for the monocytic lineage as it may also be expressed by neutrophil-committed cells and its use is not common in flow cytometry laboratories; however, it can be assessed by immunohistochemistry, or the other monocytic markers can establish the monocytic commitment.
Blasts from all cases included in this study showed unequivocal evidence of myeloid and B- or T-lymphoid commitment as shown by the expression of lineage-specific antigens. Only very rare cases showed involvement of the 3 lineages or of the 2 main lymphoid lineages. The 2 latter groups were very infrequent, accounting for a total of 6% of MPAL cases while the cases with a B + My immunophenotype accounted for more than half and those with a T + My immunophenotype for more than a third of the patients. This is in contrast to the recently reported pediatric series where a T + My immunophenotype was the most frequently found.11 Only rare cases with trilineage differentiation have been previously described4,6,11,12 and a case with a B + T-lymphoid immunophenotype with a complex karyotype has been documented.21 The 4 cases included here with such a dual-lymphoid immunophenotype had clear evidence of commitment to both lymphoid lineages and did not merely represent precursor T-ALL with expression of CD10 or weak expression of CD79a or precursor B-ALL with unusual expression of CD7 or CD2.22
Although the putative cell of origin in MPAL is unknown, it is possible that this leukemia arises in a very early hemopoietic progenitor with potential to undergo either on myeloid or lymphoid differentiation or rarely B- and T-cell differentiation. The recognition of MPAL cases with features of B- and T-cell commitment would support the proposed model of adult BM hemopoiesis where a common lymphoid (B and T) progenitor is present.23 Accordingly, the cases with a B + My and T + My immunophenotype would be in agreement with findings documented in fetal mice hemopoiesis that suggest the persistence of a myeloid potential in early B- and T-lymphoid precursors24-26 and the existence of a multipotent progenitor with B-cell, T-cell, and granulocyte/macrophage but no or little erythroid/megakaryoblastic potential.27
The majority of blasts from MPAL cases showed, in addition to the expression of myeloid- and lymphoid-restricted markers, reactivity with MoAbs that detect antigens in early hemopoietic stem cells such as CD34 and CD117, reinforcing further the early stage of differentiation of the blasts.
Our results also substantiate the robustness of the EGIL scoring system for the diagnosis of MPAL. Only a minority of cases included here would not have been classified as MPAL according to the EGIL scores. Conversely, we excluded here only 2 cases because of the presence of t(8;21), another with dysplasia and “secondary” AML and 11 cases because of the lack of MPO expression or monocytic differentiation (data not shown).
We also observed a high incidence of cytogenetic abnormalities in MPAL with only 13% of the cases displaying a normal karyotype. However, no single cytogenetic abnormality was clearly overrepresented indicating that MPAL does not result from a unique recurrent genetic abnormality. In this series, we could allocate 28% of cases into the 2 subcategories proposed by the WHO, that is, MPAL with t(9;22)/BCR-ABL1 and MPAL with 11q23/MLL rearrangements, with the remaining cases classified as MPAL NOS. The most common abnormalities found were a complex karyotype with a relatively frequent involvement of chromosome 6q and abnormalities of chromosomes 5 and 7. A few cases of BAL have been previously documented as having 6q abnormalities5,6 and involvement of chromosomes 5 and 7 have also been reported.5-8,10,11 In our cohort of patients, the presence of the Ph chromosome or BCR-ABL1 rearrangement was less frequent than a complex karyotype. The Ph chromosome has been described in BAL4-7 but in our study it was not exclusively restricted to adults with a B + My immunophenotype as previously suggested, but also detected in a few patients with a T + My immunophenotype and/or children. Another abnormality involving the 11q23/MLL gene was detected in a small proportion of patients and it was preferentially, but not exclusively, found in children with a B + My immunophenotype. The t(4;11) is more often seen in ALL than in AML. A workshop on hematologic malignancies with the t(4;11)(q21;q23) showed that 34% of these patients were infants and 95% of cases had ALL, 4.5% were AML with only 1 case having “biphenotypic” acute leukemia.28 Although MLL rearrangements have been described in mixed lineage acute leukemias,11 most of the patients with this abnormality have a precursor B-ALL with aberrant expression of myeloid antigens, particularly CD15 and CD65 but not MPO.29,30 In addition, most of these cases have a pro-B/B-I-ALL or less frequently a pre-B/B-III immunophenotype.30 In contrast to the t(4;11), the t(11;19)(q23;p13) translocation is more common in AML. However, it may also be seen in ALL when the breakpoint is at 19p13.3 and could be related to previous exposure to topoisomerase type II inhibitors.31 Five of our 6 cases with 11q23 rearrangement had immunophenotypic features of late B-cell differentiation with 2 cases displaying a common/B-II-ALL immunophenotype, 1 a pre-B/B-III-ALL immunophenotype, 1 a T-cell immunophenotype, and only 1 a pro-B-ALL immunophenotype. Two patients were infants and 3 of 6 had AML morphology, with monocytic differentiation in 2 cases. No case had previous exposure to topoisomerase type II inhibitors. Among other abnormalities, trisomy 4 was detected in 2 patients with a T + My and B + My immunophenotype. This abnormality has been reported in 1 patient with MPAL and a T + My immunophenotype.9 A recent study in pediatric cases classified according to the EGIL criteria has shown a relatively high incidence of EVT6/RUNX1 rearrangement in contrast to this series in which this abnormality was rarely present (2 cases). Although detailed immunophenotypic data were not given in the study by Gerr et al,12 it is likely that at least several of these cases represented ALL with aberrant myeloid antigen expression.
Data on gene expression profiling are scanty and limited. Of 13 pediatric cases reported by Rubnitz et al,11 8 appear to have a signature different from AML and B- or T-lineage ALL. The remaining 5 clustered with AML; however, of these latter 5 cases, 3 corresponded to AML with lymphoid antigen expression (CD2+, CD7+, CD3−) and not MPAL.
Reports on the outcome of patients with MPAL are limited. Published studies have documented the poor outcome of BAL in terms of achieving CR and survival4,7,10 and suggested that these are related to association with unfavorable markers such as p-glycoprotein over-expression and unfavorable karyotype.4,10 However, these results need to be taken with caution because of the patients' heterogeneity and/or the small numbers included.4,7,10 The present study is neither a prospective nor a randomized study but the patients were treated with very similar and uniform protocols and 2 main prognostic markers in acute leukemias such as age and cytogenetics were considered. On this basis, our findings suggest that ALL-directed treatment seems more effective with a higher response rate and better outcome compared with an AML or to an AML + ALL schedule. A recent study focused on 33 MPAL pediatric patients has also shown a high CR rate for ALL (83%) compared with AML-oriented (52%) therapy, and no differences in outcome compared with a pediatric AML group but a poorer outcome compared with ALL.11 Despite these findings, the authors suggested the use of AML-based regimens as front line and if CR is not achieved a switch to ALL-targeted treatment. Our data suggest that in the prognostic risk assessment 2 other variables might be considered as strong predictors for outcome: age and the presence of Ph chromosome.
In summary, we document the disease features of a large series of patients with the rare form of acute leukemia designated MPAL. We demonstrate that this leukemia has a poor prognosis particularly in adults and/or those with a Ph chromosome. MPAL patients should be considered candidates for consolidation with intensive chemotherapy and stem cell transplantation at first remission, particularly in those who achieve CR but remain positive for minimal residual disease. Prospective studies analyzing global gene expression profiling in a large cohort of well characterized MPAL are warranted as they will shed insights into the pathogenesis of the disease, by providing relevant information of deregulated genes which may, in turn, be putative therapeutic targets.
The publication costs of this article were defrayed in part by page charge payment. Therefore, and solely to indicate this fact, this article is hereby marked “advertisement” in accordance with 18 USC section 1734.
Authorship
Contribution: E.M. designed the study, analyzed the data, collected information, and wrote the manuscript; W.F.P., M.v.V., A.A., G.H., M.C.B., A.P., A.O., and P.L. collected patient information, immunologic and cytogenetics data, and oversaw the manuscript; R.M. supervised and provided flow cytometric data; J.S. supervised and provided cytogenetic data; S.A. performed statistical analysis; and H.S., R.S., and W.-D.L. contributed to the study design and to manuscript preparation.
Conflict-of-interest disclosure: The authors declare no competing financial interests.
Correspondence: Dr Estella Matutes, Haemato-Oncology Unit, Royal Marsden Hospital, 203 Fulham Rd, London SW3 6JJ, United Kingdom; e-mail: estella.matutes@icr.ac.uk.